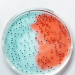
Sub Baru Varian Covid-19 XE, XD, dan XF

TERAPI dari penyakit maksiat harus kita ketahui agar bisa meminimalisir kita melakukan perbuatan dosa. Seperti diketahui, maksiat bukanlah suatu hal remeh. Sebisa mungkin, kita harus berusaha untuk menjauhi perbuatan tersebut.
Baca Juga: 30 Cara Selamat dari Maksiat
Terapi dari Penyakit Maksiat
Al-Imam Ibnu Qudamah al-Maqdisi rahimahullah berkata,
العلة الموجبة لمرض البدن لا تعالج إلا بضدها، إن كانت من حرارة فبالبرودة وإن كانت من البرودة فبالحرارة، فكذلك الأخلاق الرذيلة التي هي من مرض القلب، علاجها بضدها، فيعالج مرض الجهل بالعلم، ومرض البخل بالسخاء، ومرض الكبر بالتواضع، ومرض الشره بالكف عن المشتهى.
وكما أنه لابد من احتمال مرارة الدواء، وشدة الصبر عن المشتهيات لصلاح الأبدان المريضة، فكذلك لابد من احتمال المجاهدة، والصبر على مداومة مرض القلب بل أولى، فإن مرض البدن يخلص منه بالموت، ومرض القلب عذاب يدوم بعد الموت أبدا
“Sakit yang menimpa tubuh seseorang tidaklah diobati melainkan dengan lawannya. Jika penyakit tersebut panas, maka diobati dengan obat yang mendinginkan, jika penyakitnya dingin, maka dengan obat yang membuatnya panas.
Demikian pula akhlak jelek yang ini merupakan penyakit hati, obatnya adalah lawannya. Obat penyakit kebodohan adalah ilmu, obat penyakit bakhil adalah sifat dermawan, obat penyakit sombong adalah rendah hati dan obat penyakit melakukan kejelekan adalah menahan diri dari keinginan untuk melakukannya.
Sebagaimana hal yang harus dilakukan adalah menahan dari pahitnya obat dan kesabaran yang sangat dari keinginan melakukan perkara yang dilarang (pantangannya), agar tubuh yang sakit ini menjadi baik, maka demikian pula merupakan keharusan untuk bersungguh-sungguh dan bersabar terus-menerus mengobati penyakit hati.
Hendaknya lebih diperhatikan karena sesungguhnya sakit yang diderita pada tubuh akan berakhir pada kematian sedangkan penyakit hati akan menuai azab yang terus menerus dalam waktu yang sangat lama.”
[Cms]
Sumber:
Mukhtashar Minhāj al-Qāshidīn, jilid 1, hlm. 154.
Alih bahasa:
Abu Fudhail Abdurrahman ibnu Umar
https://t.me/alfudhail